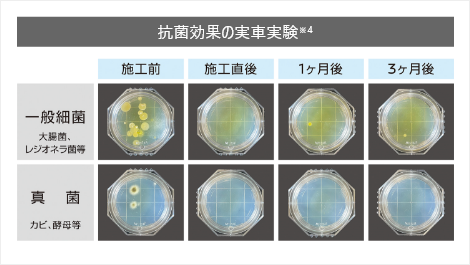

ひたちなか昭和通り店です

季節の変わり目、気温の寒暖差激しいですね

自称暑がりの私は防寒対策は一切せず
暑い暑いと息巻いていたら
しっかり風邪をひきました

乾燥する季節になると、インフルエンザや
今年はマイコプラズマ肺炎などが流行っているそうですね

体調を崩しやすい季節ですので
皆様ご自愛ください

さて、今回は中村TA(テクニカルアドバイザー)から
そんな季節にぴったり!おすすめ商品
抗菌・抗ウイルスコート
をご紹介したいと思います


・あらゆる素材に定着するので、
車室内丸ごと抗菌・抗ウイルス加工
・細菌の増殖抑制やウイルス不活化の効果が長期間持続
・1回の施工で効果が約3ヶ月持続

二児のパパさんである中村TA は
ウイルスから家族を守るために
自家用車の点検や車検のタイミングで
必ず抗菌・抗ウイルスコートを行っています

皆様もこの季節にぴったりな抗菌・抗ウイルスコート
いかがでしょうか




